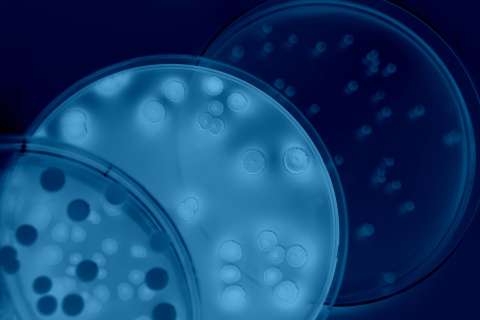
Blue cells floating against a black background

Maureen Su, MD
(she/her)
Specialty
Institutional Affiliation
Languages
Education
Fellowship
Degree
Residency
Board Certification
Contact Information
Scientific Interests
Dr. Maureen Su's research group is interested in understanding the genetics of autoimmune diseases using both mouse models and patient samples. Their work is highly translational and aims to have direct relevance to human disease. One of their approaches is to study rare Mendelian autoimmunity syndromes in order to determine the contributions of a particular gene to developing autoimmunity. They have focused on Autoimmune Polyendocrinopathy Syndrome Type 1 (APS1 or APECED), a rare condition due to mutations in the Autoimmune Regulator (Aire) gene. They are interested in how Aire promotes tolerance and have utilized both APS1 mouse models and patient samples to understand the disease mechanisms underlying this condition.
The Su group's recent studies have shown that in the course of preventing autoimmunity, Aire also prevents effective anti-tumor immunity. Furthermore, they have shown that administration of biologic inhibitors can transiently break Aire-mediated central tolerance. These findings have the potential for enhancing the efficacy of current cancer immunotherapy strategies.
Highlighted Publications
Smith CJ, Allard DE, Wang Y, Howard JF Jr, Montgomery SA, Su MA. IL-10 Paradoxically Promotes Autoimmune Neuropathy through S1PR1-Dependent CD4+ T Cell Migration. J Immunol. 2018 Mar 1;200(5):1580-1592. doi: 10.4049/jimmunol.1701280. Epub 2018 Jan 24.
Bakhru P, Zhu ML, Wang HH, Hong LK, Khan I, Mouchess M, Gulati AS, Starmer J, Hou Y, Sailer D, Lee S, Zhao F, Kirkwood JM, Moschos S, Fong L, Anderson MS, Su MA. Combination central tolerance and peripheral checkpoint blockade unleashes antimelanoma immunity. JCI Insight. 2017 Sep 21;2(18). pii: 93265. doi: 10.1172/jci.insight.93265. [Epub ahead of print]
Valenzise M, Aversa T, Salzano G, Zirilli G, De Luca F, Su M. Novel insight into Chronic Inflammatory Demyelinating Polineuropathy in APECED syndrome: molecular mechanisms and clinical implications in children. Ital J Pediatr. 2017 Jan 19;43(1):11. doi: 10.1186/s13052-017-0331-6.
Zhu ML, Bakhru P, Conley B, Nelson JS, Free M, Martin A, Starmer J, Wilson EM, Su MA. Sex bias in CNS autoimmune disease mediated by androgen control of autoimmune regulator. Nat Commun. 2016 Apr 13;7:11350. doi: 10.1038/ncomms11350.
Thrasher BJ, Hong LK, Whitmire JK, Su MA. Epigenetic Dysfunction in Turner Syndrome Immune Cells. Curr Allergy Asthma Rep. 2016 May;16(5):36. doi: 10.1007/s11882-016-0612-y. Review.